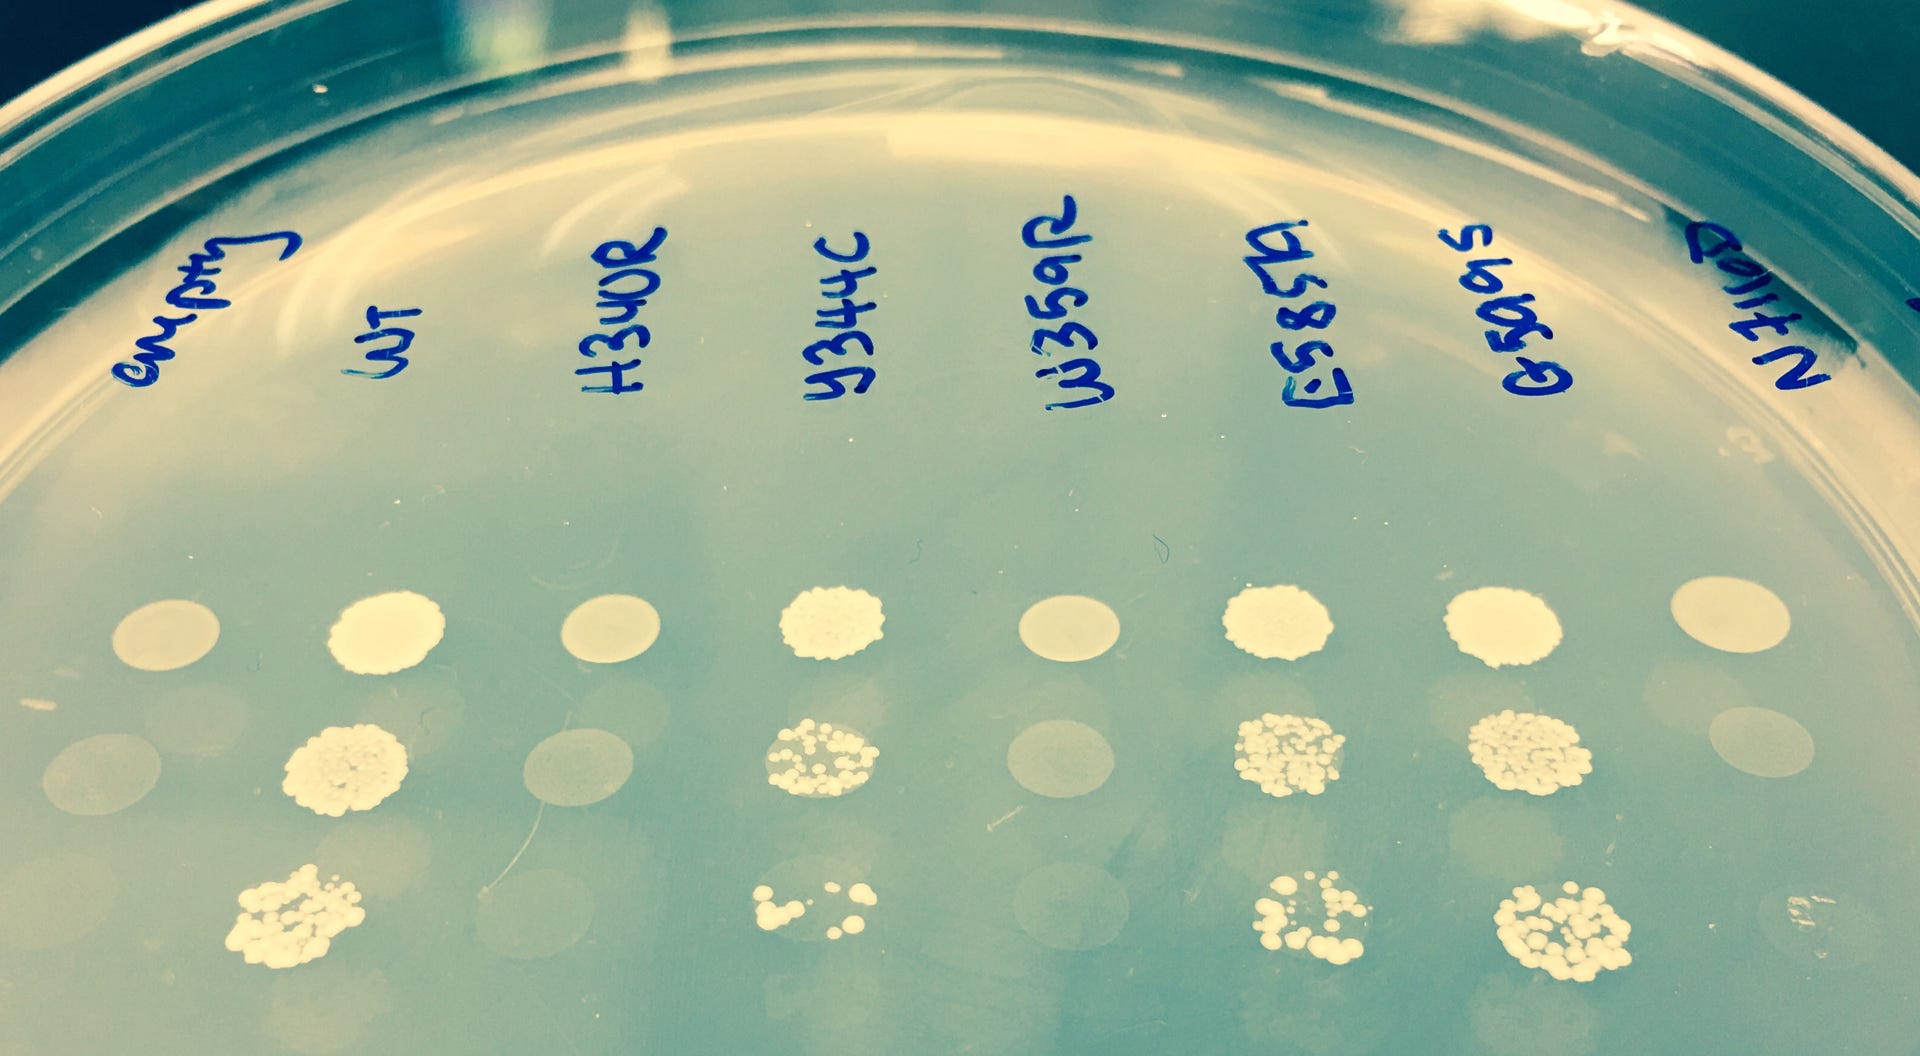

Our group is broadly interested in how human genetic variation affects gene and genome function. One area of research is grounded in the observation that mutations in aminoacyl-tRNA synthetases cause myriad disease phenotypes including dominant axonal neuropathy and recessive syndromes that include neurodevelopmental defects. A second area of research aims to study how gene regulation—via cis-acting transcriptional regulatory elements including enhancers and promoters—plays a role in the development of myelinating cells of the peripheral and central nervous systems.
tRNA Charging Enzymes and Human Inherited Disease

Aminoacyl-tRNA synthetases (ARS) are a ubiquitously expressed, essential class of enzymes responsible for attaching amino acids to cognate tRNA molecules—the first step of protein translation. Perhaps the most interesting finding regarding ARSs is that mutations in the genes encoding these enzymes cause myriad dominant and recessive disease phenotypes. Our lab is interested in addressing the following questions: (1) What is the full panel of ARS loci and alleles that cause disease? (2) What is the impact of ARS variants on gene function? and (3) How does impaired ARS activity impact protein translation? Toward this, we employ multiple experimental systems including computational analyses, molecular and cellular biology, yeast, worm, and mouse.
Transcriptional Regulation in Schwann Cells


Myelinating Schwann cells insulate and provide essential trophic factors to peripheral nerve axons. Not surprisingly, mutations in genes important for Schwann cell function cause inherited demyelinating neuropathies, which are mainly characterized by muscle weakness and sensory loss in the extremities. The transcription factor SOX10 is essential for Schwann cell function and identifying SOX10 target genes has improved our understanding of Schwann cell biology and demyelinating disease mechanisms. We our interested in addressing the following questions: (1) What is the full panel of SOX10 regulated promoters and enhancers? (2) How does SOX10 function change during myelination? and (3) What is the function of specific SOX10 target genes in Schwann cells?